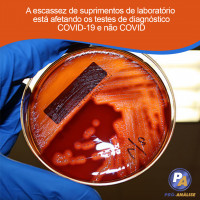
A escassez de suprimentos de laboratório está afetando os testes de diagnóstico COVID-19 e não COVID

A escassez de suprimentos de laboratório está afetando os testes de diagnóstico COVID-19 e não COVID
O teste diagnóstico é parte integrante da prestação de um bom atendimento ao paciente e do controle da disseminação de doenças infecciosas, algo que a pandemia COVID-19 demonstrou em uma escala que poucas outras pessoas conseguiram. Desde o início da primavera, a escassez de suprimentos de laboratório SARS-CoV-2 associada à alta demanda por testes COVID-19 tem impactado a cadeia de suprimentos do laboratório e forçado muitos laboratórios clínicos a articular seus esforços e redistribuir recursos. Mas agora estão surgindo relatórios de escassez de suprimentos preocupantes e sem precedentes para testes não relacionados ao COVID-19.
Quais itens de laboratório estão em falta?
Quando questionada sobre os desafios que os laboratórios clínicos estão enfrentando, a Dra. Nicole Zitterkopf, vice-presidente da Linha de Serviços Laboratoriais da Optum (a plataforma de serviços de saúde do UnitedHealth Group) em Minneapolis, Minn. Perguntou comoventemente: “Por onde eu começo? Existem vários problemas que precisam ser resolvidos aqui. ”
Muitos laboratórios ainda não têm acesso confiável aos kits de teste COVID-19, reagentes e / ou máquinas, mesmo com laboratórios normalmente bem equipados e de alta complexidade ainda incapazes de obter os kits de que precisam para executar os ensaios SARS-CoV-2. Mas agora há um novo desafio. A escassez está afetando procedimentos laboratoriais de rotina não relacionados ao COVID-19 e testes de diagnóstico para uma variedade de outras doenças, incluindo, mas não se limitando a, infecções sexualmente transmissíveis (IST), pneumonia, fibrose cística, infecção do trato urinário (UTI), gastroenterite e infecção do sítio cirúrgico.
"Os problemas da cadeia de suprimentos que os laboratórios estão enfrentando atualmente estão em constante mudança, imprevisíveis e sem precedentes", explicou o Dr. Robin Patel, ex-presidente da ASM e diretor do Laboratório de Doenças Infecciosas da Mayo Clinic em Rochester, Minnesota. Bloomberg .
Incluídos na lista em constante mudança e crescente de suprimentos difíceis de encontrar estão meios de cultura e transporte, cotonetes, pipetas, pontas de pipetas e tubos de coleta. É importante ressaltar que a maioria desses itens é usada para realizar uma variedade de procedimentos laboratoriais necessários para o atendimento de rotina ao paciente diariamente. São multifuncionais e considerados indispensáveis, em circunstâncias normais.
Por exemplo, muitos laboratórios estão relatando escassez de ágar sangue, um tipo de meio de cultura enriquecido usado para cultivar e identificar centenas de tipos diferentes de bactérias, incluindo estreptococos, enterococos e estafilococos; isso está afetando os testes de pneumonia, ITU, infecções da corrente sanguínea e, realmente, todos os tipos de infecção bacteriana.
Os laboratórios também estão relatando escassez de mídia Mueller Hinton (MH), um tipo de meio de crescimento usado para medir a susceptibilidade a antibióticos de muitas bactérias, exemplos dos quais incluem Neisseria gonorrhoeae, o agente causador da gonorréia, espécies de Acinetobacter e Enterobacteralaes, como Klebsiella pneumoniae, resistência na qual é considerada uma ameaça urgente pelos Centros de Controle e Prevenção de Doenças dos Estados Unidos (CDC). Se a susceptibilidade a antibióticos dessas e de outras bactérias não puder ser testada, os pacientes podem não receber antibióticos apropriados para suas infecções, levando a um subtratamento (e, portanto, resultados adversos, incluindo morte) ou a um tratamento excessivo (levando a distúrbios do microbioma e toxicidade desnecessária).
Outros relataram que estão prestes a ficar sem ágar chocolate, meio de cultura de fungos, meio de transporte viral, painéis vaginais, placas de ágar cromogênico, ágar seletivo para estreptococos em crescimento, caldo de soja tríptico, ágar de extrato de levedura de carvão tamponado, ágar sabouraud dextrose, calcofluor white stain e BD Max Enteric Bacterial Panels.
Como resultado dessas limitações generalizadas, muitos laboratórios estão começando a implementar soluções alternativas (embora menos eficientes, menos amigáveis ??e tecnologicamente avançadas), algumas das quais podem comprometer o atendimento ao paciente. Alguns foram forçados a recorrer a protocolos mais antigos para contornar a necessidade de suprimentos fora de estoque.
“Estamos de volta à coloração de Gram, cultura de fungos e PCR para Trichomonas vaginalis em vez de BD MAX, porque não podemos obter nenhum [BD MAX Panels]”, um laboratório compartilhado com o ASM.
Outros estão começando a restringir o teste de concentração inibitória mínima (CIM), o que pode levar a aumentos de infecções resistentes a antibióticos não identificadas e maltratadas ou, inversamente, uso excessivo de antibióticos.
Em uma nota relacionada, em 3 de setembro rd, 2020, o CDC emitiu recomendações sobre o que fazer quando o teste para DSTs (que geralmente está facilmente disponível) não está disponível, incluindo, em alguns casos, a administração de antibióticos sem fazer um diagnóstico específico sobre o que está causando a infecção.
É claro que a incerteza e a falta de suprimentos são obstáculos significativos, dificultando o dia a dia do laboratório nos Estados Unidos. Os testes de diagnóstico para todos os tipos de doenças, não apenas COVID-19, estão agora sendo afetados. Os efeitos posteriores podem ser inadequações no tratamento e cuidado do paciente, controle e contenção ineficaz de doenças infecciosas e aumento da resistência antibacteriana.
Por que está acontecendo a escassez de suprimentos de laboratório?
Acontece que essas carências são efeitos diretos e indiretos da pandemia em curso.
“Os laboratórios de referência estão sobrecarregados com o grande volume de amostras que estão recebendo”, explicou Zitterkopf. Tanto que, às vezes, alguns se recusam a aceitar novas amostras durante os picos e, se aceitarem, o tempo de resposta se estende além de 7 dias.
Entre os vários fatores associados à pandemia, a alta demanda por testes COVID-19 levou os fornecedores e fabricantes de testes clínicos a redistribuir recursos e pessoal para se concentrarem na produção de suprimentos de coleta, transporte e diagnóstico de COVID-19. Não apenas houve menos suprimentos não COVID-19 produzidos nos últimos meses, mas uma parte do estoque preexistente também foi descartada ao longo do caminho. Nos primeiros dias da pandemia, quando muitos laboratórios de pesquisa foram forçados a fechar ou restringir suas pesquisas, a demanda por mídia laminada caiu significativamente, resultando em estoque expirado que teve de ser destruído.
Não é surpreendente, então, que BD , Remel e Hardy Diagnostics, agora estão com pedidos pendentes de uma variedade de suprimentos, incluindo meios de cultura de rotina. Em resposta a essas faltas, a BD criou uma lista de produtos priorizados que concentra a produção na mídia e nos suprimentos de maior demanda, e Jay Hardy, CEO da Hardy Diagnostics declarou: “Você pode ter certeza de que estamos fazendo todo o possível para evitar pedidos pendentes. Implementamos turnos noturnos e também estamos trabalhando nos finais de semana para atender o aumento da demanda. Novo equipamento foi pedido, mas o tempo de instalação é de cerca de 6 meses. Sempre nos orgulhamos do serviço do 'dia seguinte', mas infelizmente pode demorar alguns dias a mais no momento, e por isso pedimos desculpas. ”
Como melhoramos os testes de diagnóstico para doenças COVID-19 e não COVID?
Em um esforço para identificar problemas debilitantes da cadeia de suprimentos e aliviar a tensão, o ASM fez parceria com a Association for Supply Chain Management (ASCM) para desenvolver uma plataforma online que irá monitorar e relatar a escassez e a demanda atualizadas de laboratórios. Os dados analisados de 296 laboratórios certificados pela CLIA estão sendo relatados e disponibilizados publicamente. Esta ferramenta de coleta de dados fornecerá uma visão geral detalhada da escassez mais recente de meios de cultura, reagentes, dispositivos de coleta e consumíveis que têm um impacto significativo no dia-a-dia, testes COVID-19 e não COVID-19 em um nacional, estadual e nível regional.
Publicado por https://asm.org/



